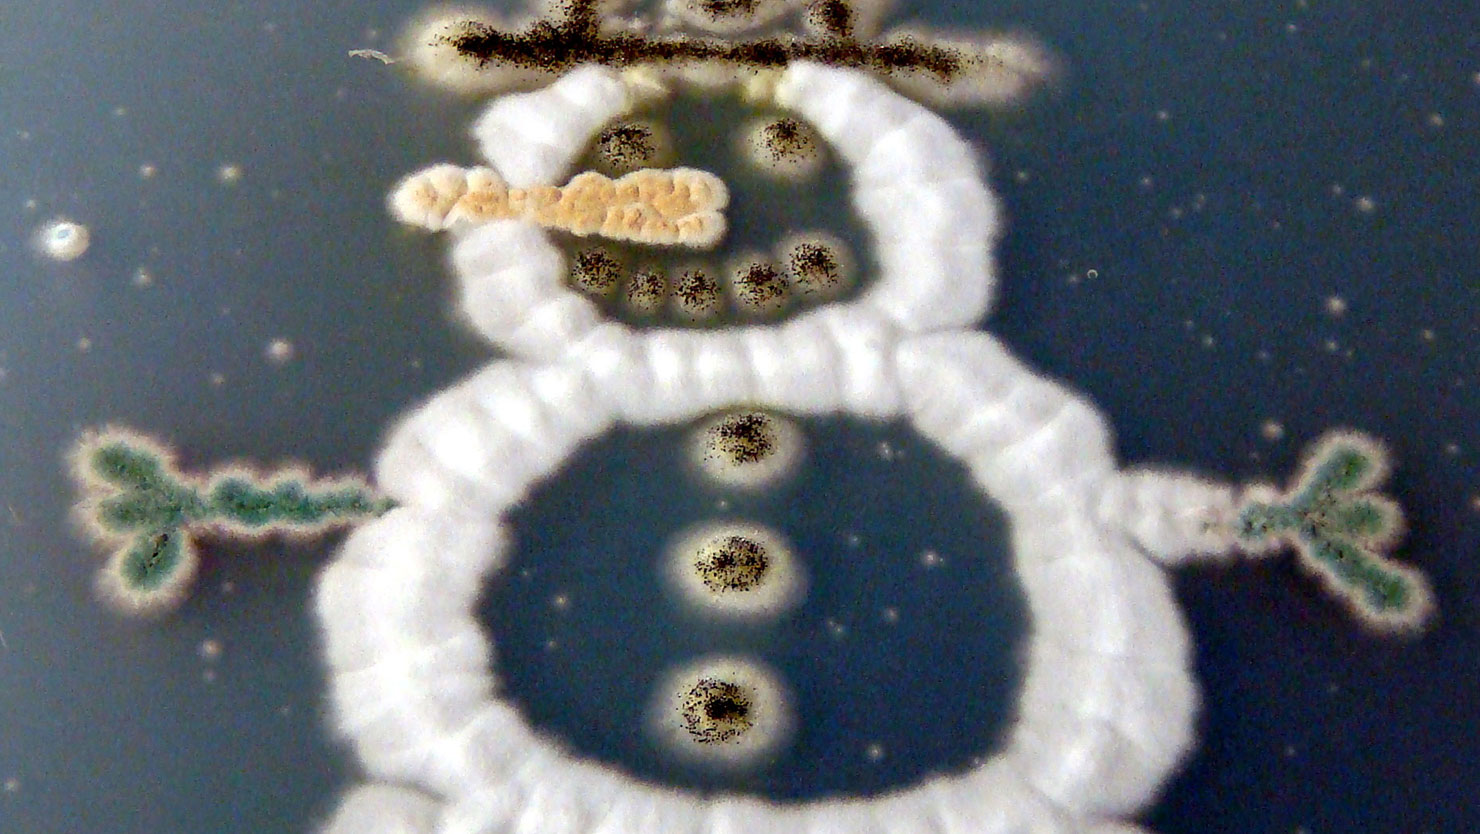
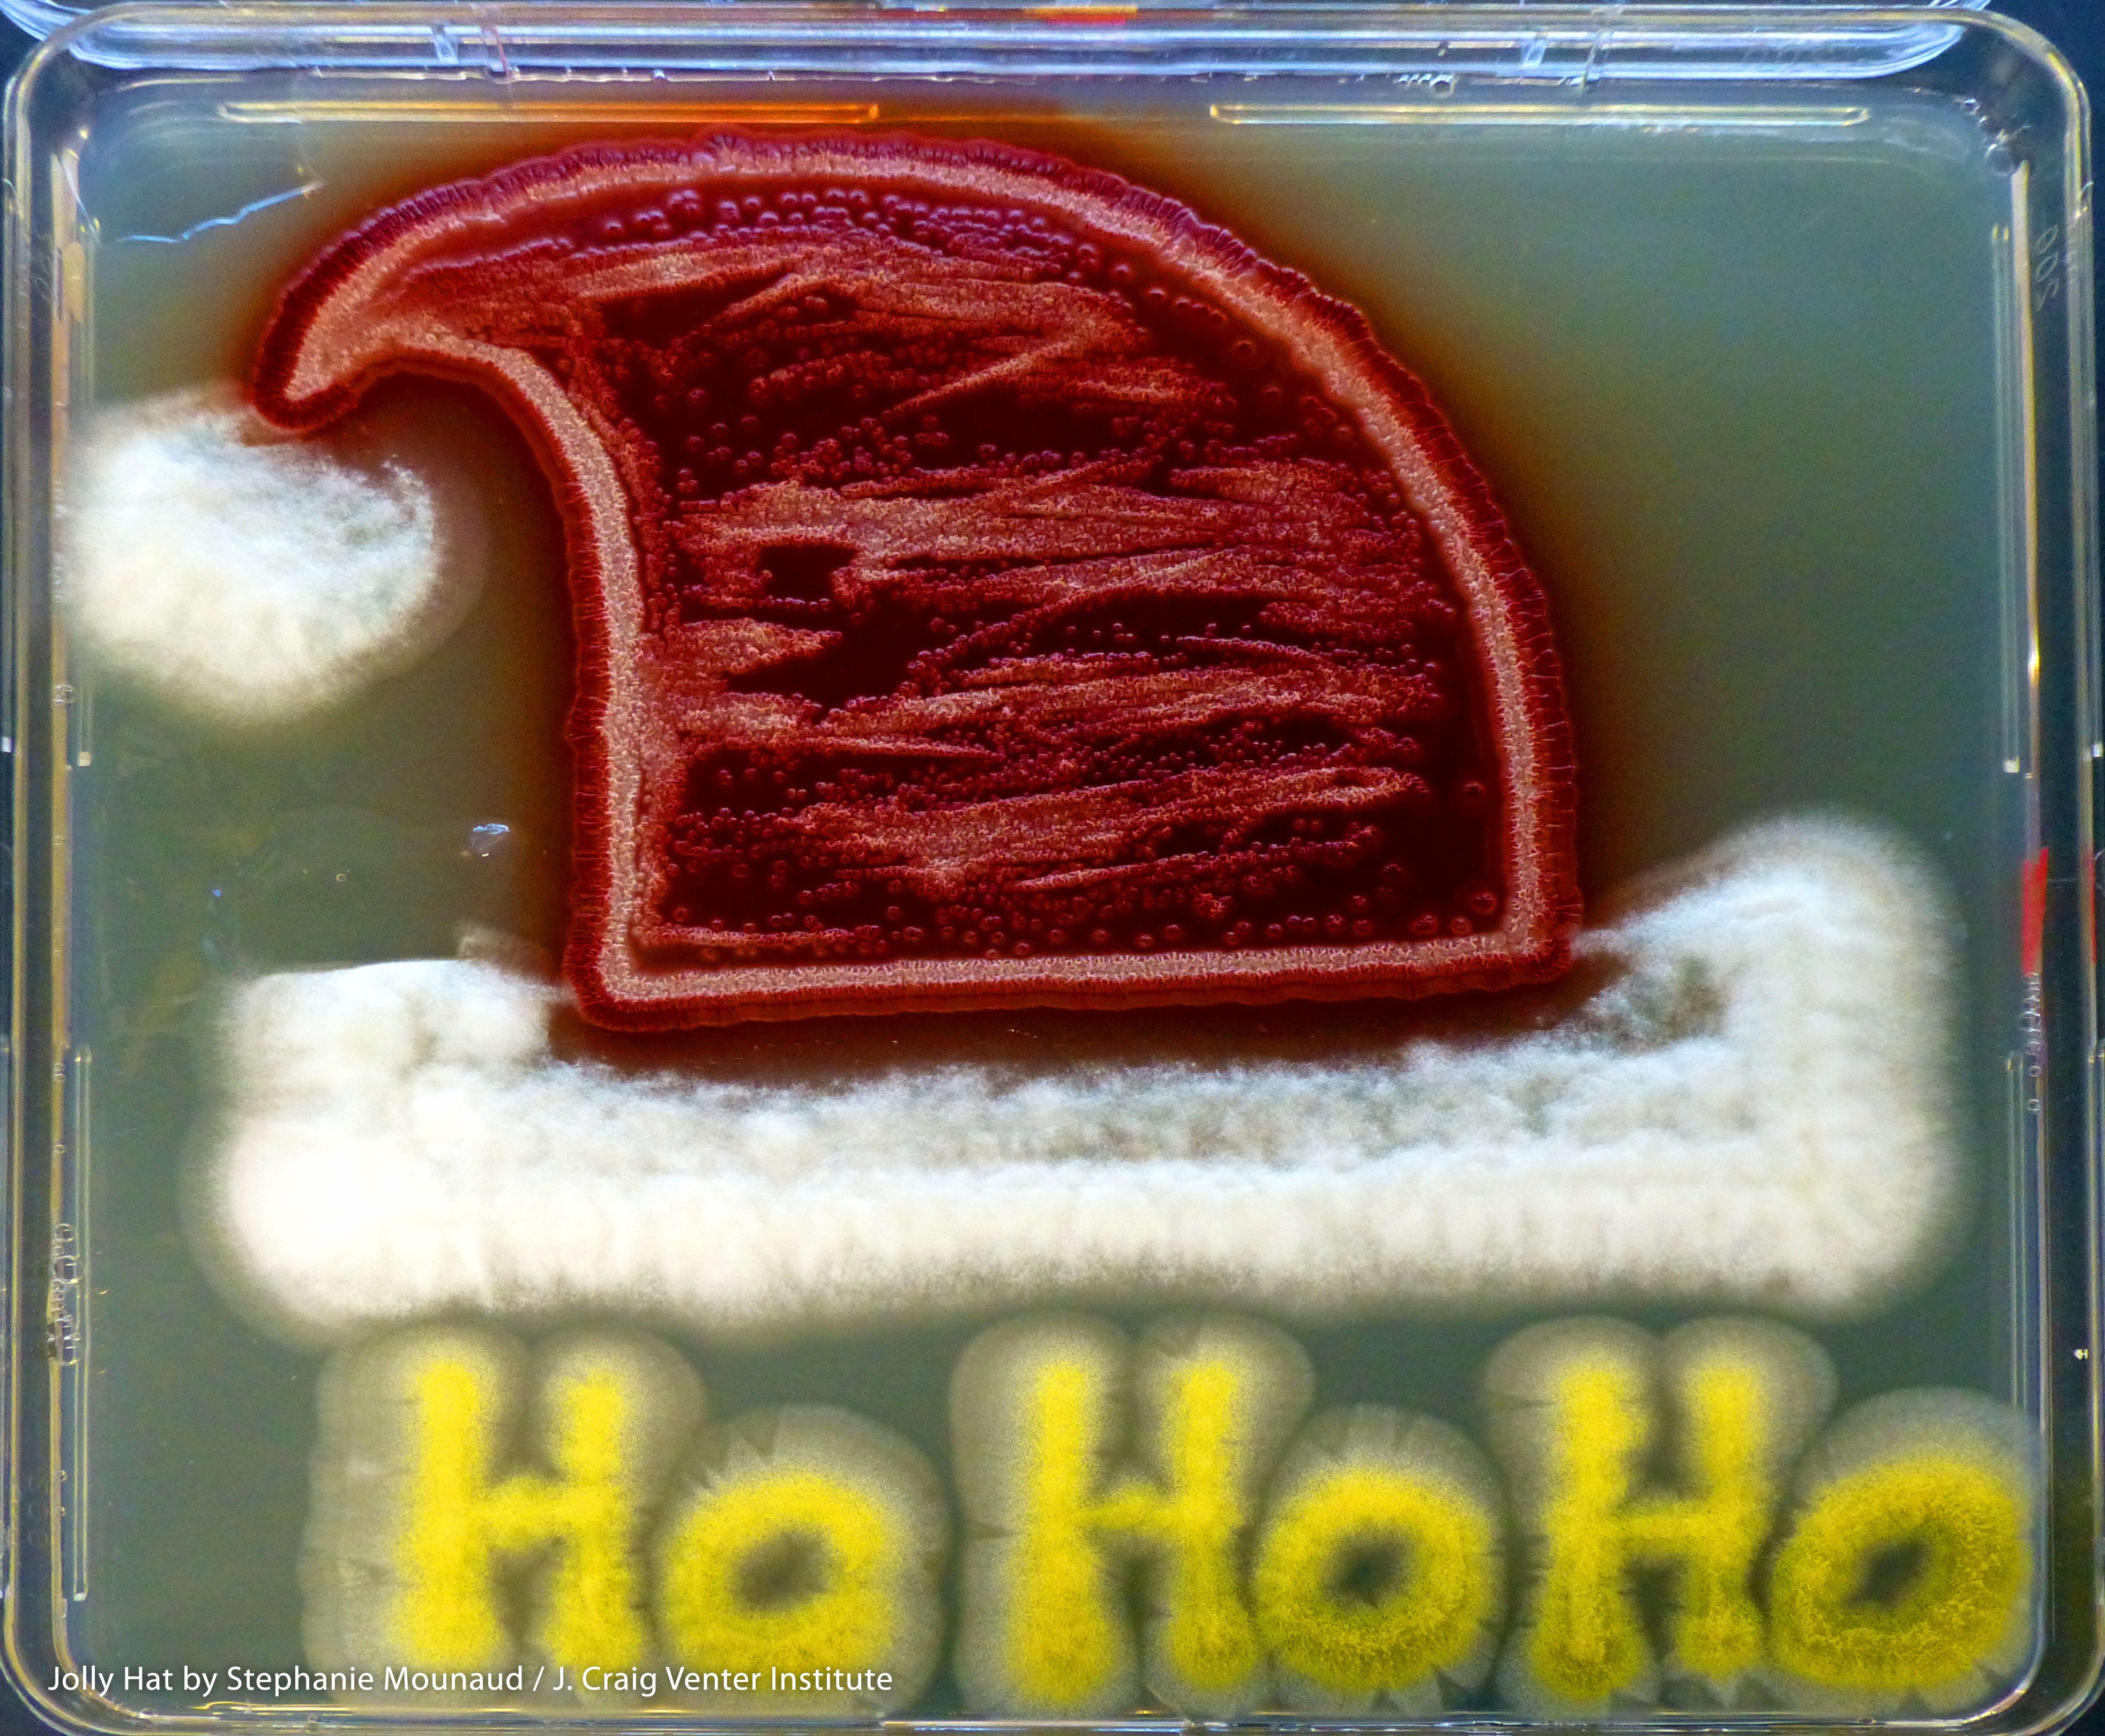
Brim and ball: Neosartorya fischeri; Hat: Penicillium marneffei; Ho,Ho,Ho: Aspergillus flavus. Image Credit: Stephanie Mounaud / J. Craig Venter Institute.
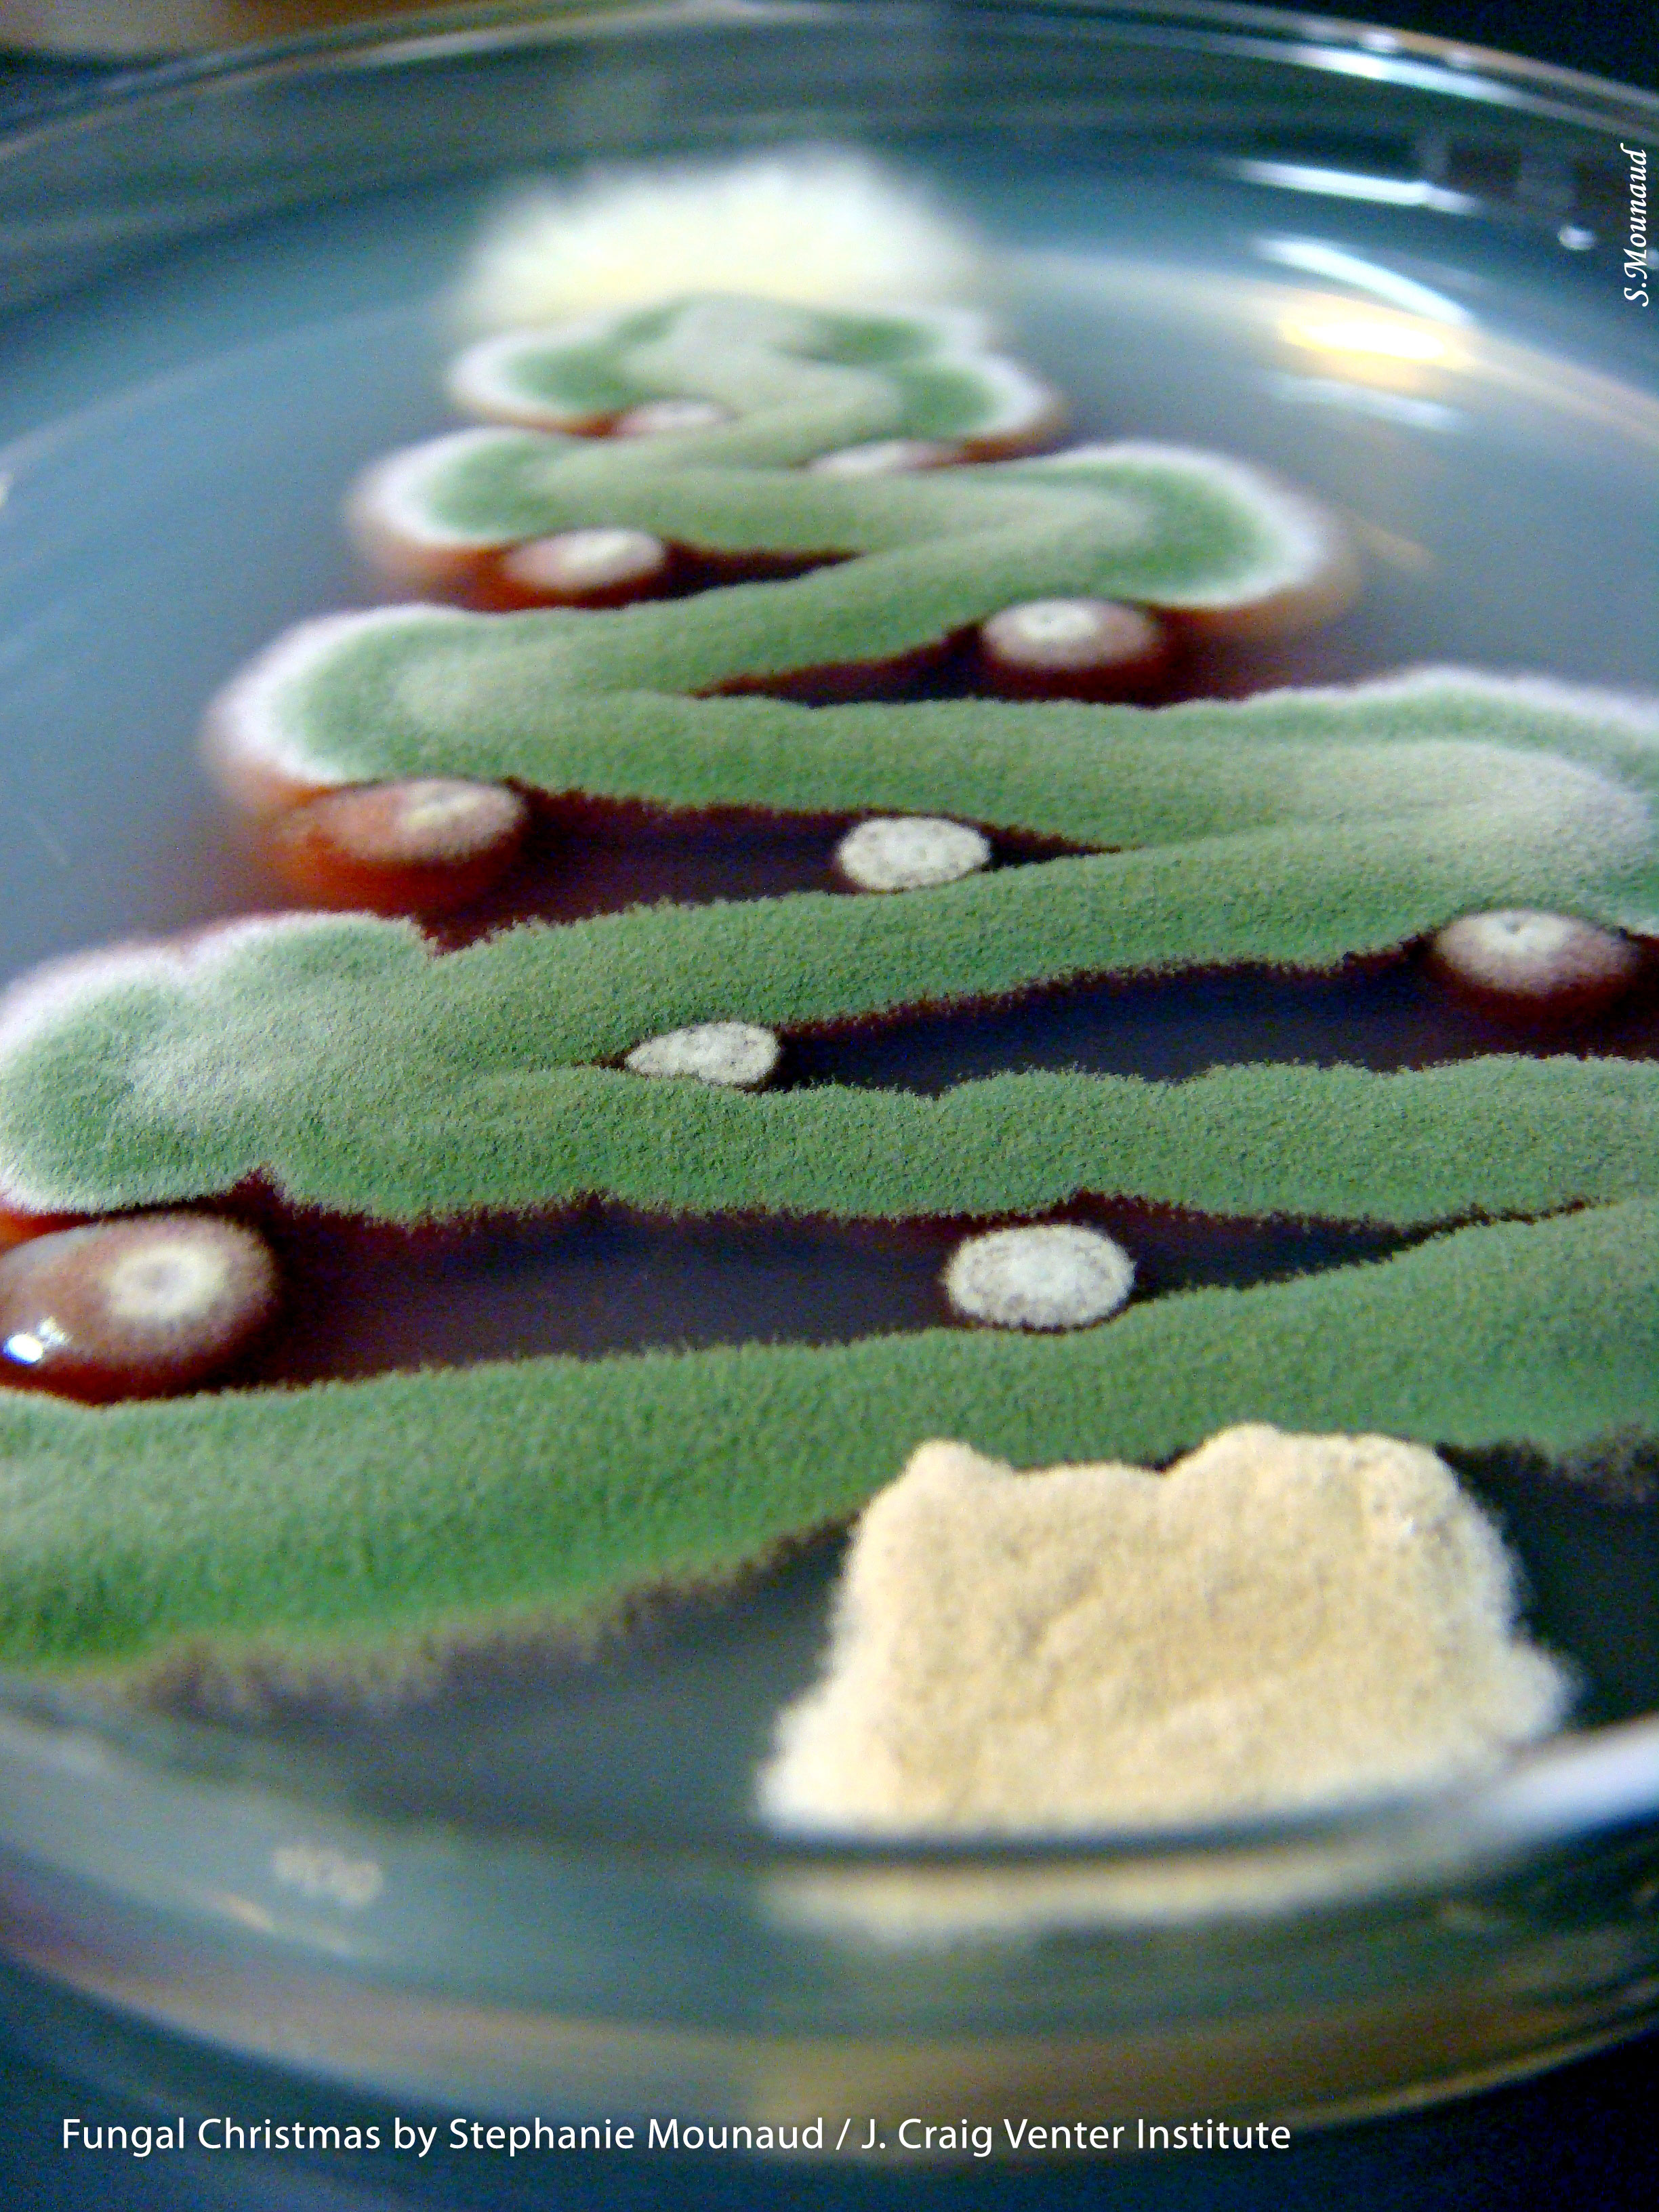
Star: Talaromyces stipitatus; Tree: Aspergillus nidulans Ornaments: Penicillium marneffei; Trunk: Aspergillus terreus. Image Credit: Stephanie Mounaud / J. Craig Venter Institute.

'Twas the night before Christmas
'Twas the night before Christmas, when all through the building
All our creatures were stirring, even our mold;
The dishes were placed in the incubator with prayer,
In hopes that pure growth soon would be there;
The scientists were nestled all close to their screens instead
While swirls of DNA danced in their heads;
My coworker in her labcoat, and I with my pipettor,
Had just settled down for a long overnighter,
When out in the lab there arose such a clatter,
I sprang from my microscope to see what was the matter.
Away to the incubator I flew like a flash,
Tore open the doors then saw what was trash.
When, what to my tired red eyes should appear,
But a bunch of contaminated plates, there goes my career.
Last year, still in an isolated fungal room placed far away from others, I made an attempt at this one, but my stocks were contaminated. Something all fungal folks know something about. (Aspergillus is just EVERYWHERE). So with a little luck (let’s face it, with complete luck) I was able to clean things up and told the fungus to be on its best behavior. However, N. fischeri still did not want to play nice with the P. marneffei…so they remained slightly separated.
I hope everyone enjoys my creation, although the credit goes to my jolly ole fungus for being so wonderfully diverse and satisfying my slightly nerdy creative side.
Let us all show the world the true side of fungus and all its amazing potential. Because we all know they can do more than just sit there and look pretty.